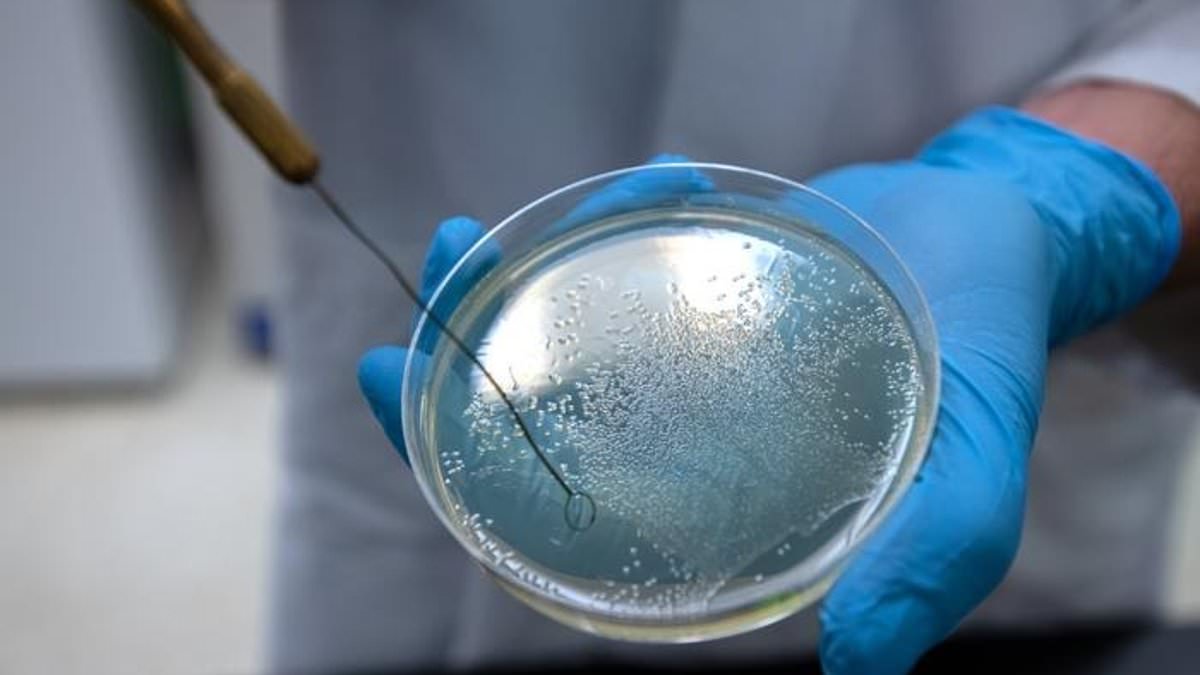
Featured image for "Bacterial Vampirism: Deadly Pathogens' Thirst for Human Blood"

WSU Grad's Disappearance Linked to Missing Idaho Man and Toddler
Nadia Erika Cole, a recent Washington State University graduate, disappeared from Seattle International Airport on May 29, the same day her fiancé Aaron Daniel Aung and his 2-year-old daughter Seraya went missing from Moscow, Idaho. An arrest warrant has been issued for Aung for first-degree custodial interference. Security footage showed Cole leaving the airport distressed, and she has not been seen since. Authorities are seeking public assistance in locating the missing individuals.